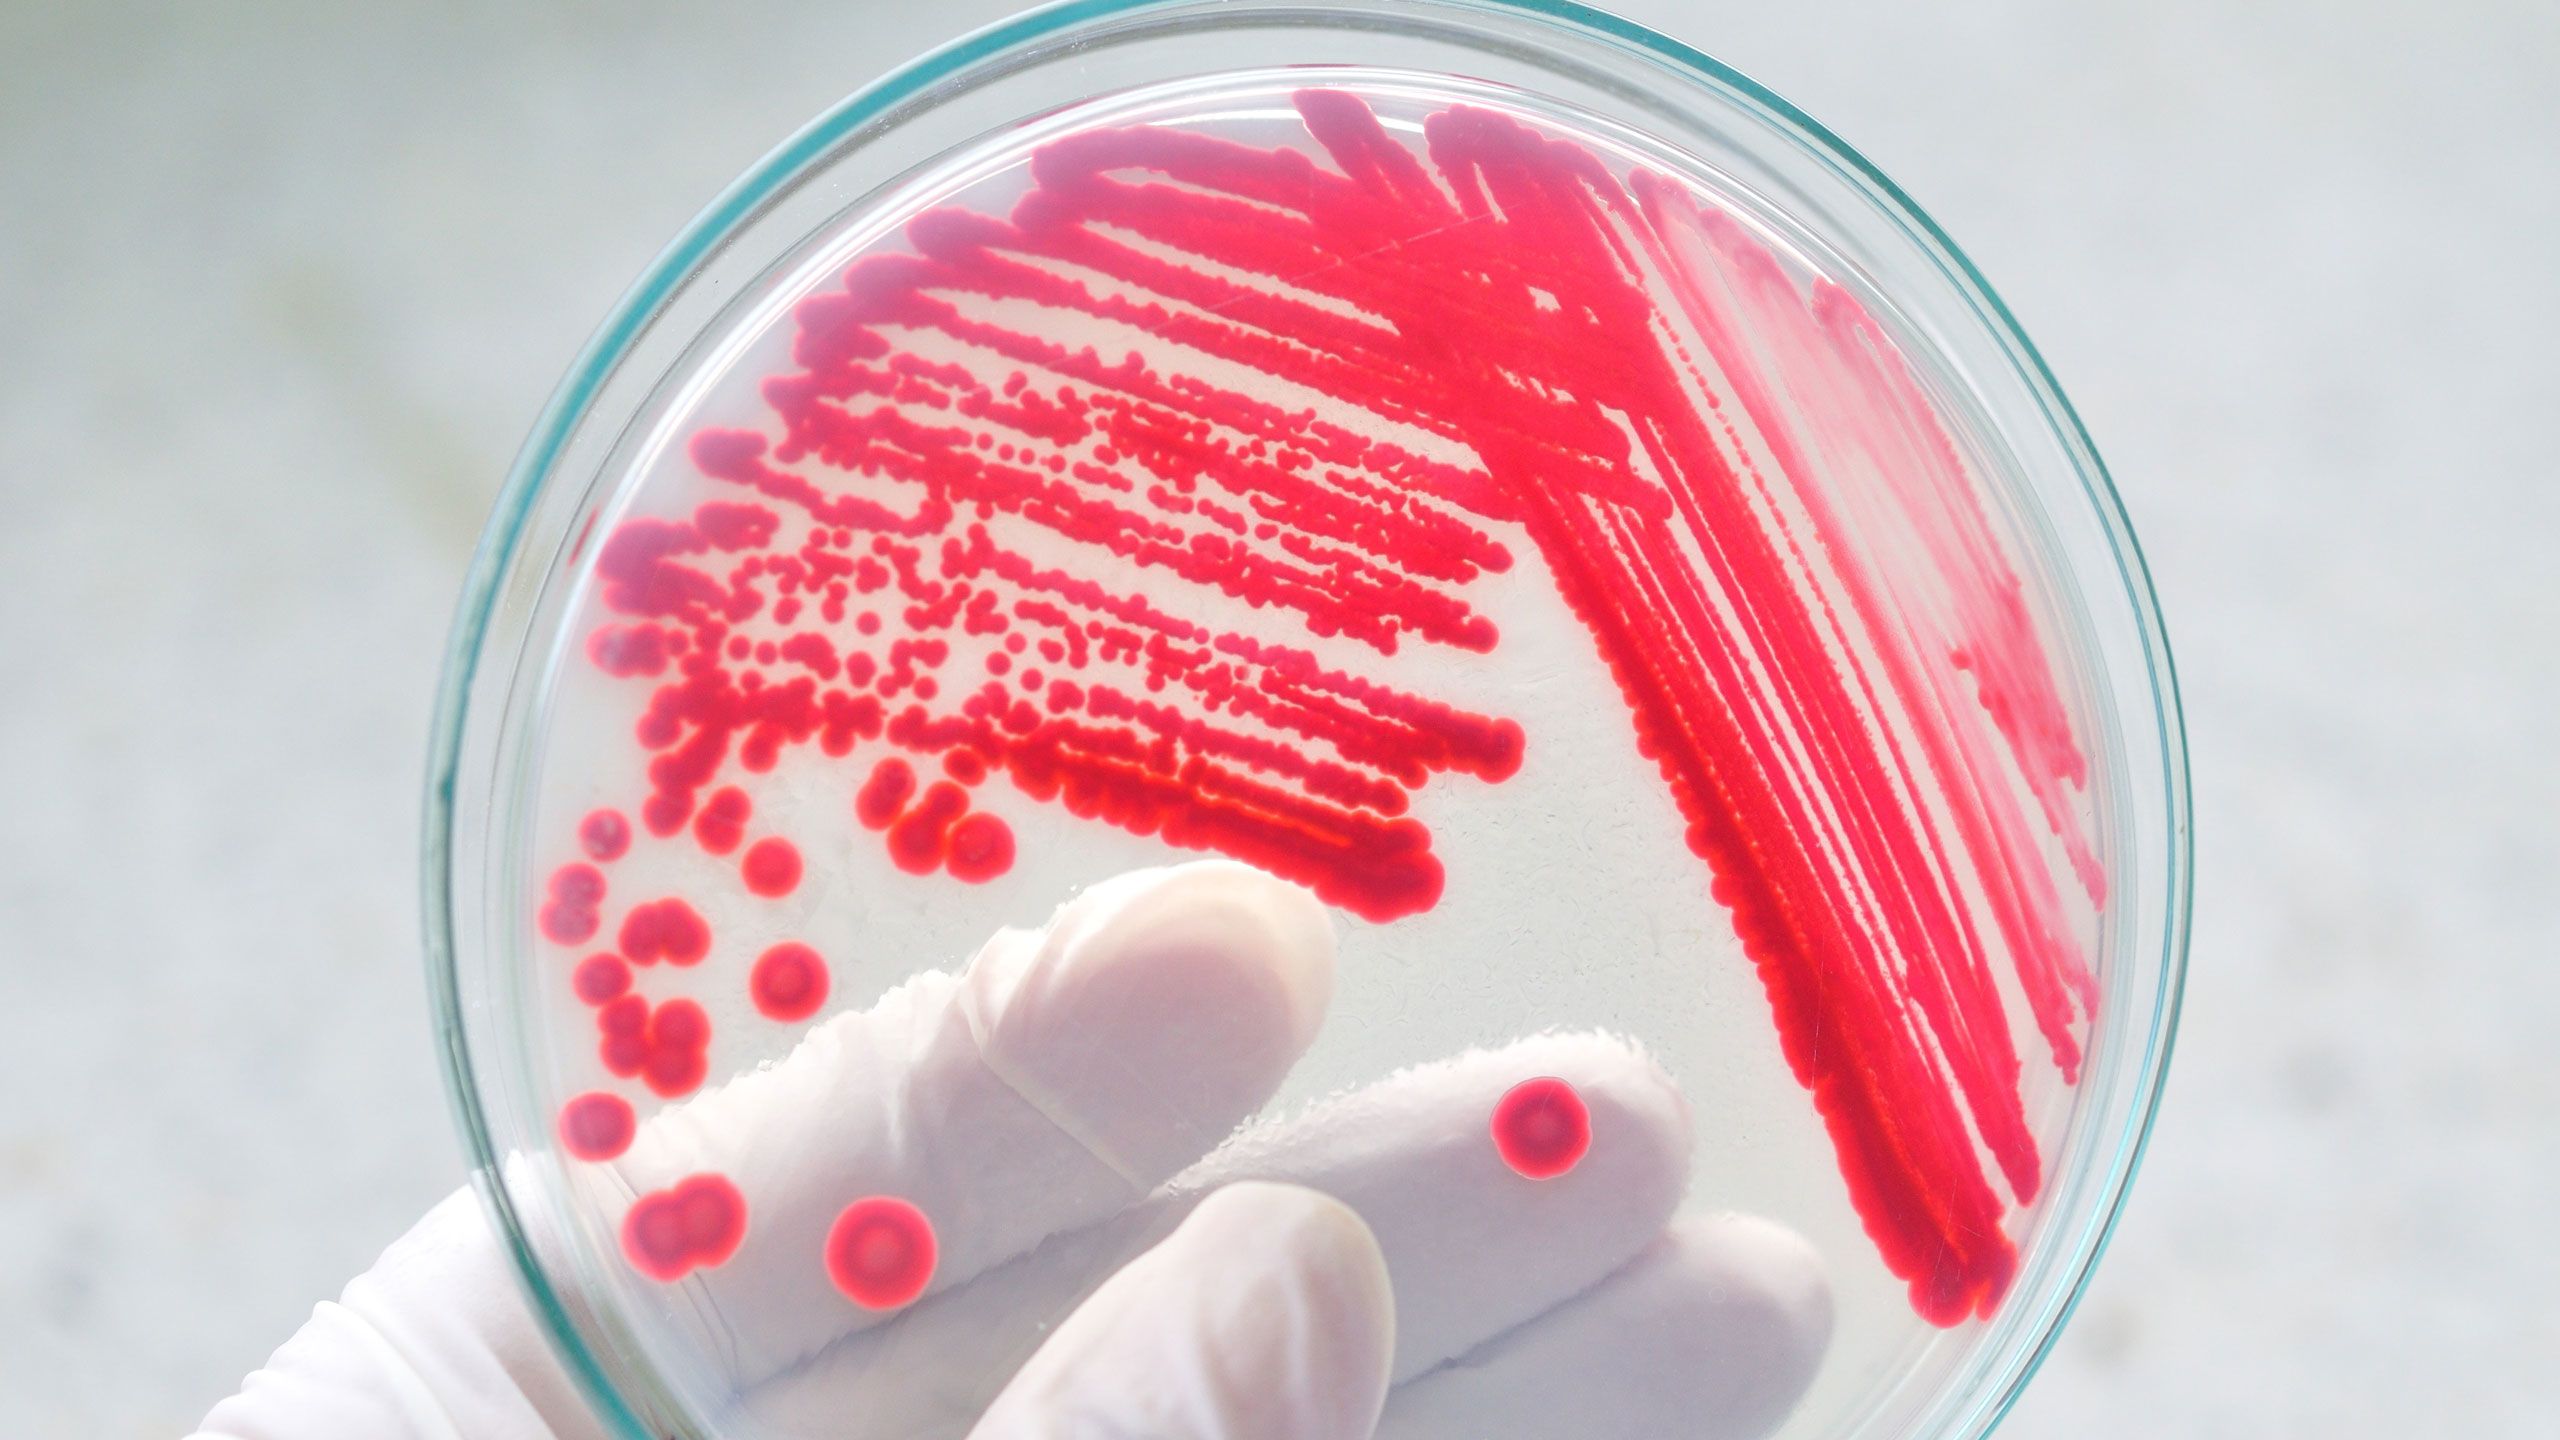

On January 2 Oskri Organics announced a recall of their Organic Sunflower Butter Tahini Butter and Thrive Sunflower Butter due to possible Listeria contamination. Dog Food Recalls.
 8 Major Food Recalls You Need To Know About Right Now
8 Major Food Recalls You Need To Know About Right Now
Bondi Protein Co Vegan Protein Bar 60g.

Latest food recalls. If you have any further questions please contact us. Coli O157H7 the US. Co-op Gold Pure brand Organic Protien Peanut Butter Crunchy recalled due to undeclared almond and Co-op Gold Pure brand Superfood Peanut Butter Crunchy recalled due to undeclared almond and cashew.
Listed below are the most current food recalls that we are aware of along with information of what to do if you have purchased a recalled product. Is Your Brand on the List. Read Food Safety News to be in.
The following list of food and consumer product recalls is not all-inclusive nor does it include all categories of food and consumer products. The list on this page represents multistate foodborne outbreak investigations since 2006 in which CDC was the lead public health agency. Recalls Market Withdrawals Safety Alerts makes available all recent recall information by product area including food drugs biological products devices and cosmetics.
Firm and Importer of Record is recalling approximately 4860 pounds of imported boneless beef products that may be contaminated with E. The company has initiated a recall of all of its products. Supermarkets including Aldi Tesco and Morrisons have issued important food recalls over the last week.
If you wish to know more about food or product recalls you can also visit the following regulatory agencies websites or you can directly contact the. Unfortunately 2019 wont be the year were finally free of food recalls. Woodwards brand Peanut Butter - Crunchy Unsalted recalled due to undeclared cashew.
To search archived content visit Search FDA Archive and input the name of. We have the best most complete list of dog food recalls. Food Safety News is a daily news source for information about food recalls foodborne illness outbreaks food science technology food policy and more.
To provide better service in alerting the American people to unsafe hazardous or defective products six federal agencies with vastly different jurisdictions have joined together to create wwwrecallsgov -- a one stop shop for US. Recent food recalls and alerts. Department of Agricultures Food Safety and Inspection Service.
Every year about 1 in 6 Americans get sick from food poisoning 128000 are hospitalized and 3000 die according to the Centers for Disease Control and Prevention CDC. Play your cards right and avoid these five items. The Recalls Market Withdrawals Safety Alerts are available on FDAs website for three years before being archived.
Plus historical recall info going back many years. Products that have been pulled from. The recall is due to the presence of an undeclared allergen peanut.
Federal officials are investigating a new Salmonella outbreak that is linked to brie and dips from Jules Foods. Subscribe to our RSS feed follow us on Facebook and Twitter or sign up to our food recall alert to be notified of new food recalls. Fully updated with every dog food recall of 2020 and 2021.
Several well-known grocery store products are the subjects of recent recalls. Items posted will be removed after a month of their posted date. WASHINGTON April 16 2021 JBS USA Food Company a Greeley Colo.
When two or more people get the same illness from the same contaminated food or drink the event is called a foodborne disease outbreak. The products were distributed in 11 different states but luckily no illnesses have been reported yet.

All The Current Food Recalls You Need To Know About Better Homes Gardens
All The Current Food Recalls You Need To Know About Better Homes Gardens
 Latest Food Recalls Led By Quorn Fears
Latest Food Recalls Led By Quorn Fears
 All The Current Food Recalls You Need To Know About Better Homes Gardens
All The Current Food Recalls You Need To Know About Better Homes Gardens
 8 Food Recalls You Need To Know About Now Eat This Not That
8 Food Recalls You Need To Know About Now Eat This Not That
 Report Reveals Recent Food Recall Trends 2018 04 20 Food Engineering
Report Reveals Recent Food Recall Trends 2018 04 20 Food Engineering
 All The Current Food Recalls You Need To Know About Better Homes Gardens
All The Current Food Recalls You Need To Know About Better Homes Gardens
 The Latest In Food Recalls What You Need To Know
The Latest In Food Recalls What You Need To Know





No comments:
Post a Comment
Note: Only a member of this blog may post a comment.